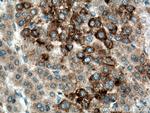
SRGAP1 Antibody in Immunohistochemistry (Paraffin) (IHC (P))

Search
Proteintech
SRGAP1 Polyclonal Antibody
{{$productOrderCtrl.translations['antibody.pdp.commerceCard.promotion.promotions']}}
{{$productOrderCtrl.translations['antibody.pdp.commerceCard.promotion.viewpromo']}}
{{$productOrderCtrl.translations['antibody.pdp.commerceCard.promotion.promocode']}}: {{promo.promoCode}} {{promo.promoTitle}} {{promo.promoDescription}}. {{$productOrderCtrl.translations['antibody.pdp.commerceCard.promotion.learnmore']}}
产品信息
13252-1-AP
种属反应
已发表种属
宿主/亚型
分类
类型
抗原
偶联物
形式
浓度
规格
纯化类型
保存液
内含物
保存条件
运输条件
产品详细信息
Immunogen sequence: MSTPSRFKK DKEIIAEYES QVKEIRAQLV EQQKCLEQQT EMRVQLLQDL QDFFRKKAEI ETEYSRNLEK LAERFMAKTR STKDHQQYKK DQNLLSPVNC WYLLLNQVRR ESKDHATLSD IYLNNVIMRF MQISEDSTRM FKKSKEIAFQ LHEDLMKVLN ELYTVMKTYH MYHAESISAE SKLKEAEKQE EKQIGRSGDP VFHIRLEERH QRRSSVKKIE KMKEKRQAKY SENKLKSIKA RNEYLLTLEA TNASVFKYYI HDLSDLIDCC DLGYHASLNR ALRTYLSAEY NLETSRHEGL D (1-300 aa encoded by BC029919)
靶标信息
The protein encoded by this gene is a GTPase activator, working with the GTPase CDC42 to negatively regulate neuronal migration. The encoded protein interacts with the transmembrane receptor ROBO1 to inactivate CDC42.
仅用于科研。不用于诊断过程。未经明确授权不得转售。
生物信息学
蛋白别名: Rho GTPase activating protein 13; Rho GTPase-activating protein 13; SLIT-ROBO Rho GTPase-activating protein 1; srGAP1
基因别名: 4930572H05Rik; ARHGAP13; KIAA1304; NMTC2; RGD1566260; SRGAP1
UniProt ID: (Human) Q7Z6B7, (Mouse) Q91Z69
Entrez Gene ID: (Human) 57522, (Rat) 314903, (Mouse) 117600